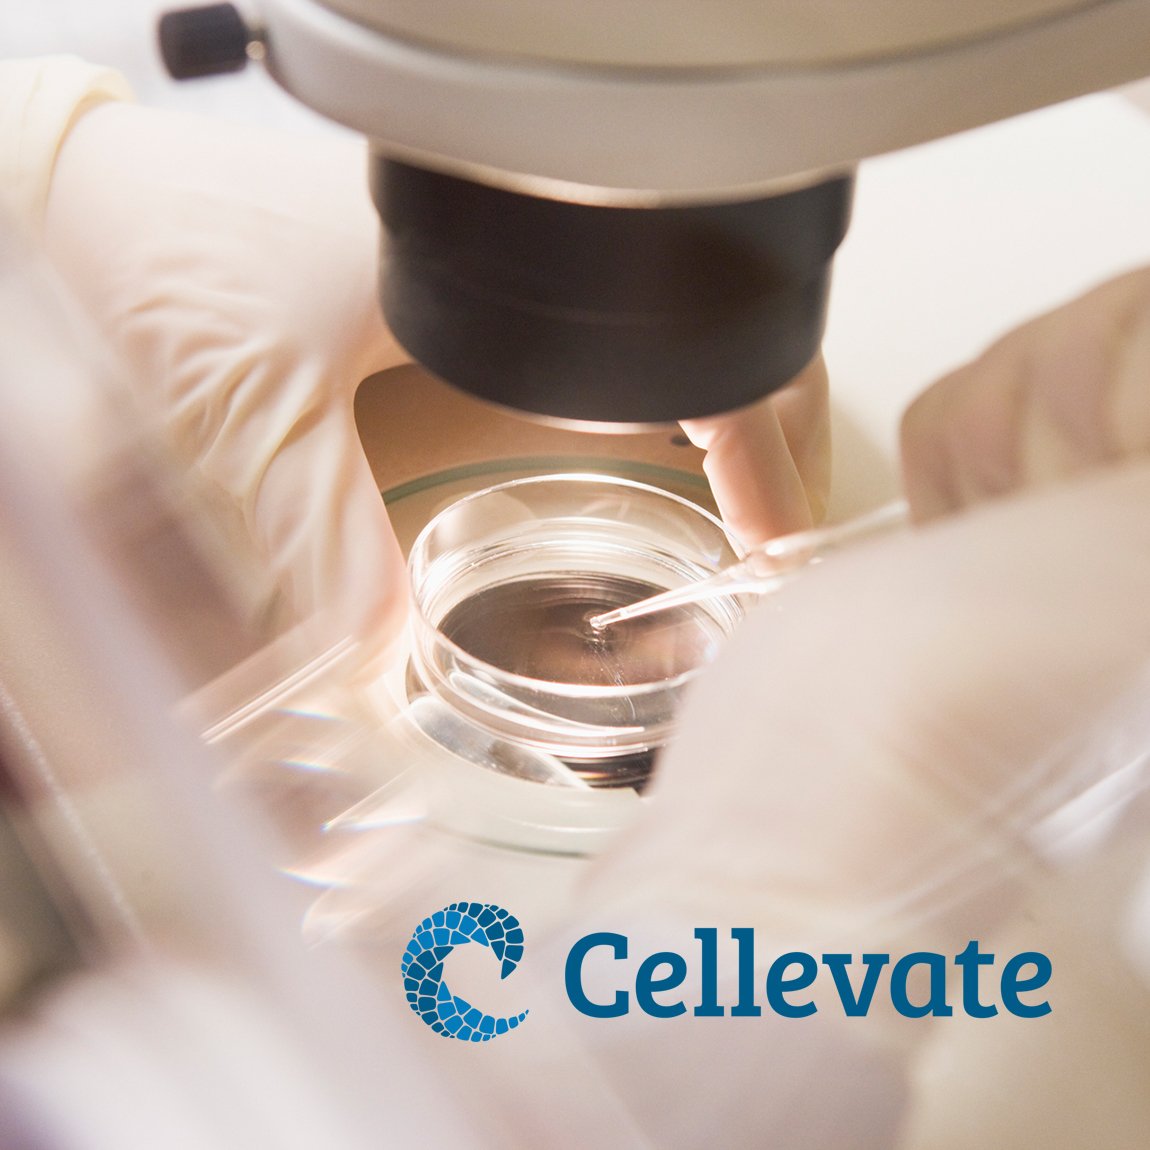

Cellevate
Utvecklar nanofibermaterial för cellodling inom biofarmaceutisk produktion
- CEO: Karsten Fjärstedt
- First investment year: 2026
- Fund: Syd
- Business sector: Life Science
Cellevate grundades i Lund 2014 och utvecklar material som används för att odla celler i produktionen av biologiska läkemedel och vaccin. Bolagets produkt, Cellevat3d, gör det möjligt att skala upp produktion från mindre laboratoriemiljöer till större industriella processer.
I dag är produktionsutbytet inom bioprocessering ofta lågt samtidigt som kostnaderna är höga, vilket skapar behov av mer effektiva produktionslösningar. Cellevates material är utvecklat för att öka utbytet i produktionen och göra det enklare att skala upp, vilket kan bidra till att fler behandlingar når patienter.
Bolaget har redan lanserat produkter på marknaden och går nu in i en fas där kunder börjar implementera tekniken i sin produktion. Kunderna finns främst inom tillverkning av biologiska läkemedel och vaccin.
Det starka deltagandet från både nuvarande och nya investerare återspeglar ett fortsatt förtroende för vår strategi och vår förmåga att ta tekniken till marknaden. Vi ser det som en bekräftelse på det arbete vi gjort hittills och en viktig grund för nästa steg i vår utveckling.
Karsten Fjärstedt, interim vd för Cellevate



